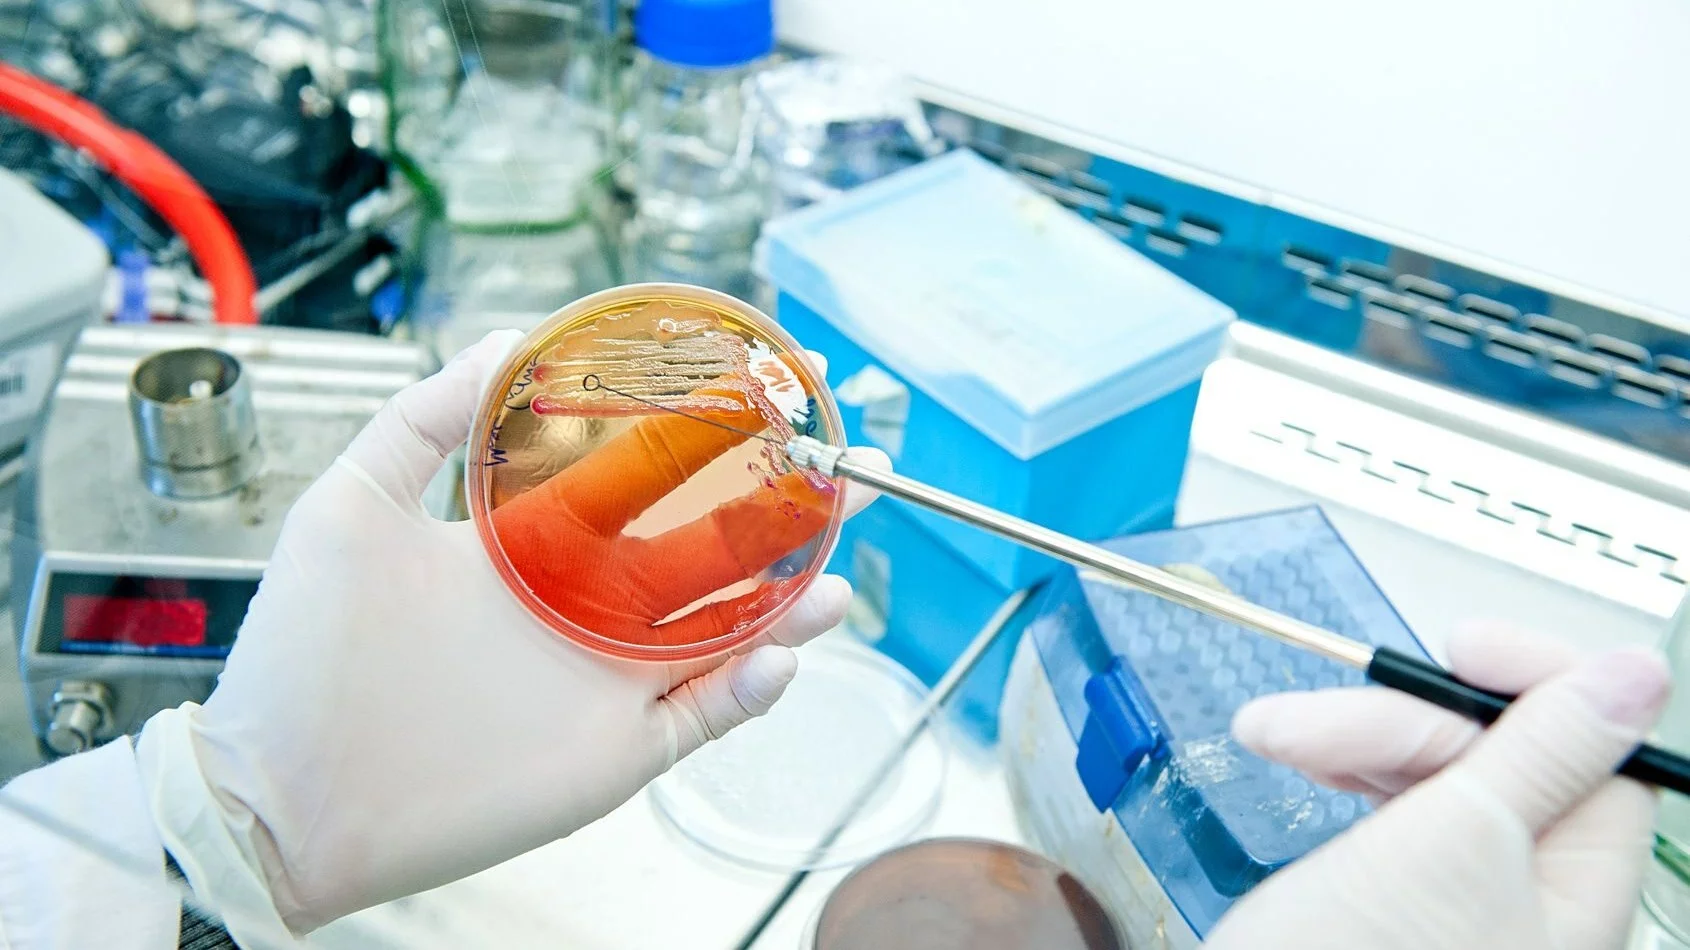
Laboratorium mikrobiologiczne

Odkrycia dokonała dr Małgorzata Pawlikowskia-Warych z Katedry Mikrobiologii US pracująca pod przewodnictwem prof. dra hab. Wiesława Deptuły. Dzięki zastosowaniu metod biologii molekularnej wykryła ona w wodach Odry bakterię z rodziny Simkaniaceae, którą określa się jako chlamydię środowiskową.
Badacze ze Szczecina jako pierwsi w Polsce stwierdzili obecność tego zarazku (OdraWCh30) w wodzie rzecznej. Wcześniej tegoi typu bakterie obserwowane były w innych krajach, takich jak Austria, Francja, Hiszpania, Izrael czy Niemcy. Dzięki badaniom naukowców z US okazało się jednak, że chlamydie środowiskowe, które są bardzo groźne dla człowieka i zwierząt, gdyż powodują m.in. schorzenia układu oddechowego, występują też w wodach Odry.
– Cały czas prowadzimy badania, dzięki którym chcemy wykazać, że chlamydie środowiskowe występują w środowisku, m. in. w wodzie i w odchodach ptaków, choć nie wykluczamy, że także w organizmach ssaków (ludzie, zwierzęta gospodarskie), co oznacza, że jest to problem poważny. Naszym zamiarem jest uruchomienie procesu diagnostycznego polegającego na opracowaniu znaczników , na bazie których będzie można prowadzić rozpoznawanie chlamydii środowiskowych. Dzięki temu mielibyśmy szansę zlikwidować przypuszczalne źródło i przyczynę wielu schorzeń wywoływanych przez te zarazki – wyjaśnił prof. dr hab. Wiesław Deptuła.
Więcej informacji na temat badań naukowców na stronie Uniwersytetu Szczecińskiego.